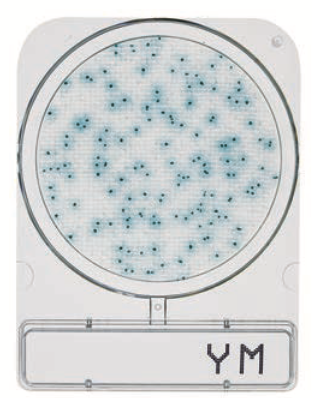
微生物快速测试片—霉菌与酵母，Compact Dry YM 1400pc
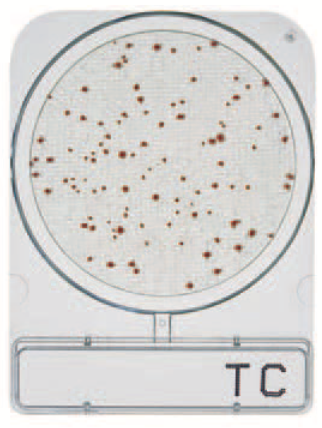
微生物快速测试片—菌落总数，Compact Dry TC 1400pc

产品中心搜索
- 仪器部件与备件 (1)
- 液相色谱仪(HPLC)部件与备件 (882)
- 液相色谱质谱联用仪(LC/MS)部件与备件 (949)
- 气相色谱仪(GC)部件与备件 (669)
- 气相色谱质谱联用仪(GC/MS)部件与备件 (394)
-
光谱仪(UV、AA、ICP)部件与备件 (1724)
- UV-1900 (98)
- UV-1800 (106)
- UVmini-1285 (37)
- UV-1780 (103)
- UV-1750 (27)
- UV-2600/UV-2700 (91)
- UV-2450/UV-2550 (46)
- UV-3600/3600 Plus (120)
- UVmini-1280 (56)
- UV-1280 (86)
- UVmini-1240 (126)
- AA-6880 (176)
- AA-7000 (136)
- AA-6300/6300C (93)
- AA-6800 (43)
- AA-6650 (174)
- ICPE-9800/9820 (76)
- ICPS-8100 (75)
- ICPS-7510 (51)
- 红外相关 (4)
- 电感耦合等离子体质谱仪(ICP-MS)部件与备件 (32)
- 总有机碳分析仪(TOC)部件与备件 (197)
- 其他仪器部件与备件 (82)
- 液相色谱柱及保护柱 (2)
-
反相/正相/HILIC色谱柱 (71)
- ShimNex CS C18色谱柱 (2)
- ShimNex HE系列色谱柱 (17)
- ShimNex WP系列色谱柱 (5)
- ShimNex UP系列色谱柱 (3)
- ShimNex WR系列色谱柱 (2)
- Shim-pack Scepter系列杂化颗粒色谱柱 (9)
- Shim-pack G系列高纯硅胶色谱柱 (13)
- Shim-pack Velox系列实心核颗粒色谱柱 (5)
- Shim-pack Arata系列高纯硅胶色谱柱 (2)
- Shim-pack VP系列高纯硅胶色谱柱 (3)
- Shim-pack FC系列高纯硅胶色谱柱 (1)
- Shim-pack XR系列高纯硅胶色谱柱 (6)
- SHIMSEN Ankylo系列色谱柱 (1)
- SHIMSEN SuperbⅡ系列 (1)
- 尺寸排阻色谱柱 (16)
- 离子交换色谱柱 (12)
- 离子色谱柱 (8)
- SFC色谱柱 (9)
- 液相色谱柱制备柱 (10)
- 流动相杂质捕集柱 (4)
- 液相色谱柱专用柱 (17)
- 其它色谱柱 (5)
- 液相色谱柱保护柱 (35)
- 气相毛细管色谱柱 (42)
- 气相毛细管色谱柱专用柱 (22)
- PLOT及金属气相毛细管色谱柱 (23)
- 气相毛细管色谱柱保护柱 (6)
- 固相萃取柱 (57)
- QuEChERS产品 (9)
- 免疫亲和柱 (13)
- 生物样品前处理 (7)
- 样品前处理相关装置 (3)
- 一步法净化小柱 (2)
- 同位素内标 (2683)
- 混标标准品 (439)
- 仪器试剂标准品 (70)
- 特色标准品试剂 (97)
- 热点项目标准品试剂 (486)
- 过滤产品 (13)
- 样品瓶及溶剂瓶 (22)
- 移液器及分液器 (5)
- 安全防护 (2)
- 进样针 (5)
- 比色皿 (3)
- 石墨管 (4)
- 空心阴极灯 (1)
- 管路及接头 (2)
- 方法包 (18)
- 采样产品 (2)
- 岛津分析仪器选配 (9)
- 实验室通用设备 (6)
- 其他小型仪器设备 (11)
- 微生物检测耗材 (50)
- 细胞培养 (18)
货号:070-51093-42中文名:接头英文名: CONNECTOR,B2L3.5/8LH 174834 使用机型:LCMS-2020包装规格:数量1其他参数:...
登录会员可看价格
货号:070-51093-41中文名:接头英文名: CONNECTOR,B2L3.5/6LH 174833 使用机型:LCMS-2020包装规格:数量1其他参数:...
登录会员可看价格
货号:070-03623-02中文名:电缆英文名:RS232C 1500MM使用机型:GCMS-TQ8030/TQ8040包装规格:数量1其他参数:088-50906-11已停产,替代货号:070-03623-02。长度1.5米...
登录会员可看价格
货号:070-03623-02中文名:电缆英文名:RS232C 1500MM使用机型:GCMS-QP2010/QP2010S/QP2010Plus包装规格:数量1其他参数:088-50906-11已停产,替代货号:070-03623-02。长度1.5米...
登录会员可看价格
CompactDry 微生物快速测试片使用方法CompactDry 微生物快速测试片应用领域及特点CompactDry 微生物快速测试片采样方式CompactDry 微生物快速测试片霉菌与酵母快速型CompactDry 微生物快速测试片自动计数...
登录会员可看价格
CompactDry 微生物快速测试片使用方法CompactDry 微生物快速测试片应用领域及特点CompactDry 微生物快速测试片采样方式CompactDry 微生物快速测试片副溶血性弧菌CompactDry 微生物快速测试片自动计数...
登录会员可看价格
CompactDry 微生物快速测试片使用方法CompactDry 微生物快速测试片应用领域及特点CompactDry 微生物快速测试片采样方式CompactDry 微生物快速测试片霉菌与酵母CompactDry 微生物快速测试片自动计数...
登录会员可看价格
CompactDry 微生物快速测试片使用方法CompactDry 微生物快速测试片应用领域及特点CompactDry 微生物快速测试片采样方式CompactDry 微生物快速测试片大肠菌群CompactDry 微生物快速测试片自动计数...
登录会员可看价格
CompactDry 微生物快速测试片使用方法CompactDry 微生物快速测试片应用领域及特点CompactDry 微生物快速测试片采样方式CompactDry 微生物快速测试片大肠菌群与大肠埃希氏菌CompactDry 微生物快速测试片自动计数...
登录会员可看价格
CompactDry 微生物快速测试片使用方法CompactDry 微生物快速测试片应用领域及特点CompactDry 微生物快速测试片采样方式CompactDry 微生物快速测试片菌落总数CompactDry 微生物快速测试片自动计数...
登录会员可看价格